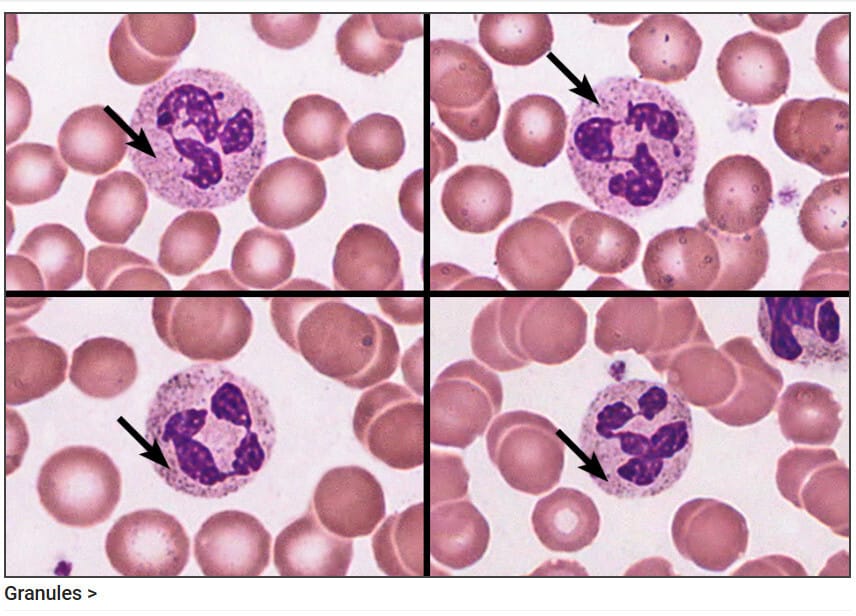

Table of Contents
혈액의 성분 (Component of Blood)
혈액(Blood)은 원심분리기(centrifuge)를 사용해 층별로 분리할 수 있습니다. 원심분리기는 혈액을 빠르게 회전시켜, 무거운 구성 요소가 아래로, 가벼운 구성 요소가 위로 이동하도록 합니다. 혈액의 성분에 대해 간략히 정리해보겠습니다.
원심분리된 혈액은 총 세 개의 층으로 나뉩니다.

- 맨 아래층: 적혈구(Erythrocytes)
- 중간층: 버피 코트(Buffy coat) – 혈소판(Platelets)과 백혈구(Leukocytes)
- 맨 위층: 혈장(Plasma)
적혈구 (Erythrocytes)

적혈구는 전체 혈액의 약 45%를 차지하며, 이 비율은 헤마토크릿(Hematocrit)이라 불립니다. 적혈구는 산소를 조직으로 운반하고 이산화탄소를 폐로 가져가 배출되도록 합니다.
적혈구는 가운데가 오목한 형태(biconcave disc)로, 산소 및 이산화탄소 교환을 효율적으로 수행할 수 있는 구조로 이루어져있습니다. 핵과 같은 세포 소기관이 없어 헤모글로빈(Hemoglobin) 단백질을 더 많이 포함할 수 있지만, 이로 인해 수명이 약 120일로 제한됩니다. 적혈구는 지속적으로 골수에서 재생됩니다.
버피 코트 (Buffy Coat)
버피 코트는 적혈구 위 얇은 층으로, 혈소판과 백혈구가 포함됩니다. 이 층은 전체 혈액 부피의 약 1% 미만을 차지하며, 대부분은 백혈구로 구성됩니다.
혈소판 (Platelet)

혈소판은 골수에서 거대핵세포(Megakaryocytes)에서 떨어져 나온 작은 조각들로, 손상된 혈관을 밀봉하여 혈액 손실을 막는 플러그를 형성합니다.
백혈구 (Leukocytes)
백혈구는 병원균, 암세포, 독소를 제거하는 데 중요한 역할을 합니다. 이들은 과립구(Granulocytes)와 무과립구(Agranulocytes)로 나뉘며, 과립구에는 호중구(Neutrophils), 호산구(Eosinophils), 호염기구(Basophils)가 포함됩니다. 무과립구에는 림프구(Lymphocytes)와 단핵구(Monocytes)가 포함됩니다.


과립구와 비과립구
| 항목 | 과립구 (Granulocytes) | 비과립구 (Agranulocytes) |
| 정의 | 세포질에 과립(Granules)이 포함된 백혈구 종류 | 세포질에 과립이 없는 백혈구 종류 |
| 종류 | 호중구(Neutrophils) 호산구(Eosinophils) 호염기구(Basophils) | 림프구(Lymphocytes) – B세포 – T세포 – 자연살해세포(NK cells) 단핵구(Monocytes) |
| 주요 기능 | 염증 반응에서 첫 번째 방어선 역할 병원체(세균, 기생충 등) 제거 알레르기 반응 유발 (특히 호염기구) | – 적응면역담당 항체 생성 및 면역 기억 형성 (림프구) -포식 작용으로 병원체 제거 (단핵구) |
| 비율 | 전체 백혈구의 약 65~70% 차지 | 전체 백혈구의 약 30~35% 차지 |
| 핵의 형태 | 분엽형(다엽형 핵; Lobed nucleus) | 단일형 핵(Round or kidney-shaped nucleus) |
| 기타 특징 | 세포질 과립 내에 염증 유발 물질 포함 | 혈액을 떠나 조직으로 이동해 작용 (특히 단핵구 → 대식세포로 분화) |
혈장 (Plasma)

혈장은 전체 혈액의 약 55%를 차지하며, 세포가 없는 층입니다. 혈장의 약 90%는 물로 구성되어 있으며, 나머지는 단백질, 전해질, 가스 등이 포함됩니다.
알부민 (Albumin)
알부민(Albumin)은 혈장에서 가장 풍부한 단백질로, 간에서 생성되며, 삼투압을 유지하고 지방산, 칼슘, 지용성 호르몬 등의 물질을 운반합니다.
글로불린 (Globulins)
또한, 혈장의 글로불린(Globulins)에는 병원균을 제거하는 항체 역할을 하는 감마글로불린(Gamma globulins)이 포함됩니다.
피브리노겐 (Fibrinogen)
혈장의 또 다른 중요한 단백질인 피브리노겐(Fibrinogen)은 혈관 손상 시 혈소판을 결합시켜 혈전 형성을 돕습니다.
요약
혈액은 약 45%의 적혈구, 55%의 혈장, 그리고 1% 미만의 혈소판과 백혈구로 구성됩니다. 각 구성 요소는 신체의 항상성을 유지하고, 감염을 예방하며, 손상된 조직을 복구하는 데 중요한 역할을 합니다. 각 혈액의 성분별로 따로 자세히 다루겠습니다.
Resource
- https://en.wikipedia.org/wiki/Blood_components
- Image by Servier Medical Arts , Licensed Under CC BY 4.0, https://smart.servier.com/


